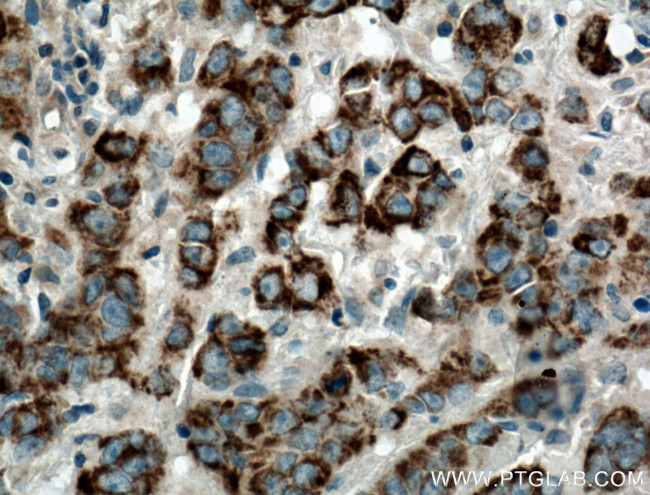
DEC1 Antibody in Immunohistochemistry (Paraffin) (IHC (P))
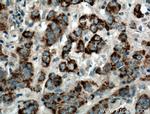
DEC1 Antibody in Immunohistochemistry (Paraffin) (IHC (P))

Search
Proteintech
DEC1 Polyclonal Antibody
{{$productOrderCtrl.translations['antibody.pdp.commerceCard.promotion.promotions']}}
{{$productOrderCtrl.translations['antibody.pdp.commerceCard.promotion.viewpromo']}}
{{$productOrderCtrl.translations['antibody.pdp.commerceCard.promotion.promocode']}}: {{promo.promoCode}} {{promo.promoTitle}} {{promo.promoDescription}}. {{$productOrderCtrl.translations['antibody.pdp.commerceCard.promotion.learnmore']}}
产品信息
25021-1-AP
种属反应
宿主/亚型
分类
类型
抗原
偶联物
形式
浓度
规格
纯化类型
保存液
内含物
保存条件
运输条件
产品详细信息
Immunogen sequence: MTMNVLEAG KWKSIVPAPG EGLLAVLHMM VFTDALHRER SVKWQAGVCY NGGKDFAVSL ARPKAAEGIA D (1-70 aa encoded by BC153139)
靶标信息
Dec1, which is also known as Stra13 or Sharp2, is a basic helix-loop-helix (bHLH) transcription factorthat has beenfound to play an important role in circadian system. Dec1contains one basic helix-loop-helix (bHLH) domain, one Orange domain and is reported to be expressed in Treg cells. It is also reported that Dec1 is required for long-term maintenance of Treg cells after adoptive transfer to suppress effector T cell-mediated inflammation. Dec1 positively regulates CD25 expression in association with Runx 1.
仅用于科研。不用于诊断过程。未经明确授权不得转售。
生物信息学
基因别名: CTS9; DEC1
Entrez Gene ID: (Human) 50514